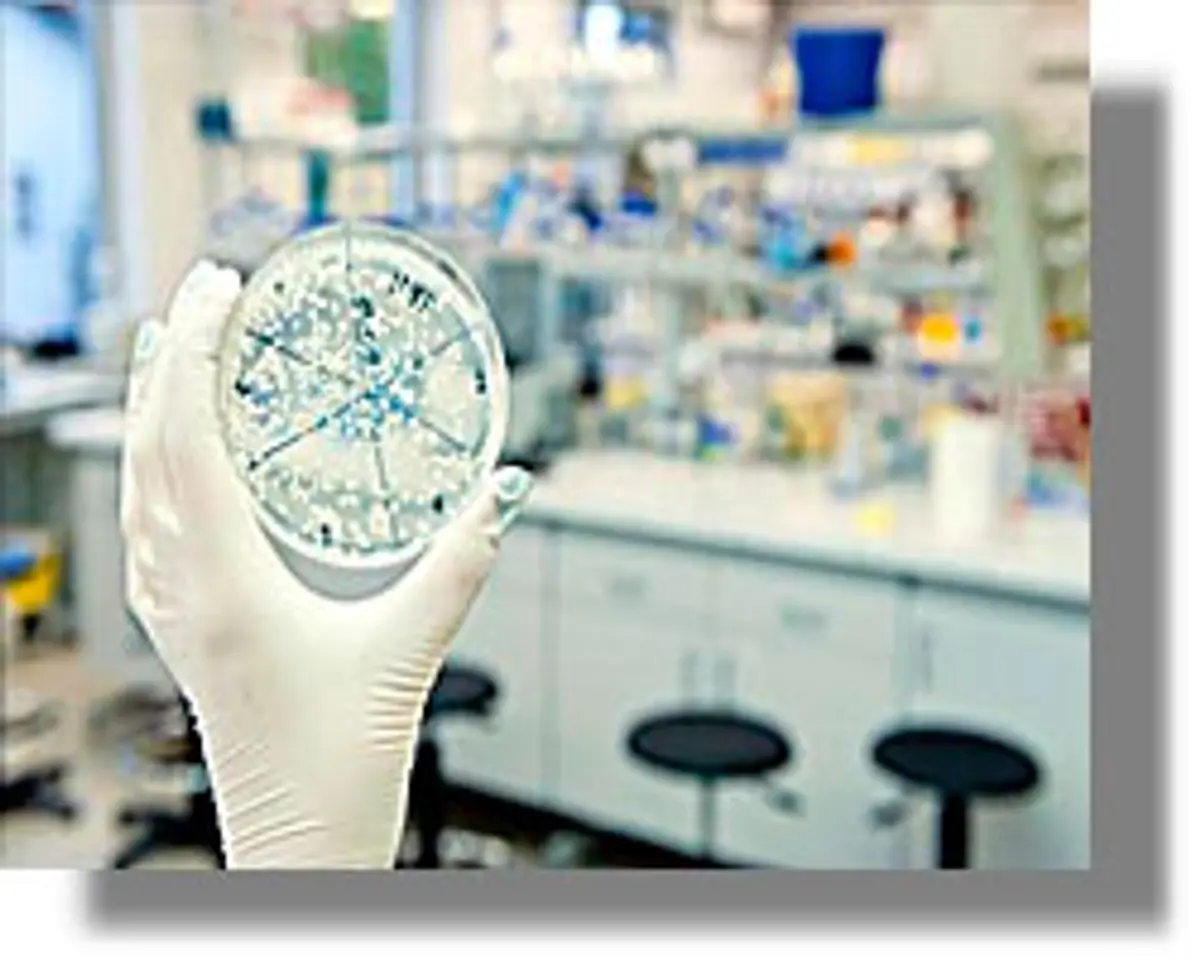
γαστρεντερίτιδα Δωδεκάνησα

ΜΕ ΜΕΤΑΔΟΣΗ ΚΥΡΙΩΣ ΑΠΟ ΑΤΟΜΟ ΣΕ ΑΤΟΜΟ
Διευκρινίσεις για την έξαρση κρουσμάτων γαστρεντερίτιδας που σημειώθηκε σε ξενοδοχειακή μονάδα της Ρόδου, δίνει το Κέντρο Ελέγχου και Πρόληψης Νοσημάτων (ΚΕ.ΕΛ.Π.ΝΟ.), το οποίο από τις 14 Αυγούστου, σε συνεργασία με τη Διεύθυνση Δημόσιας Υγείας και Κοινωνικής Αλληλεγγύης της Περιφερειακής Ενότητας Δωδεκανήσου και τα Εργαστήρια του δικτύου των Εργαστηρίων Δημόσιας Υγείας ξεκίνησε τη διερεύνηση.
«Με τα έως τώρα δεδομένα πιθανολογείται επιδημία ιογενούς γαστρεντερίτιδας με μετάδοση κυρίως από άτομο σε άτομο. Πιθανός αιτιολογικός παράγοντας θεωρείται ο νοροϊός, ο οποίος ευθύνεται για περισσότερες από 200 εκατομμύρια λοιμώξεις το χρόνο στις χώρες του Δυτικού κόσμου», αναφέρει το ΚΕΕΛΠΝΟ, επισημαίνοντας ότι το φαινόμενο βρίσκεται σε ύφεση και έμφαση αυτή τη στιγμή δίνεται στη λήψη των ενδεικνυόμενων μέτρων για την αποφυγή περαιτέρω κρουσμάτων.
Σύμφωνα με τα διαθέσιμα επιδημιολογικά δεδομένα, το φαινόμενο ξεκίνησε στις 12 Αυγούστου και αφορούσε σε ήπιας συμπτωματολογίας γαστρεντερίτιδα (έμετοι και διάρροιες διάρκειας 1-2 ημερών), τόσο σε ενοίκους όσο και σε εργαζομένους της εν λόγω ξενοδοχειακής μονάδας. Κρούσματα αναφέρθηκαν κυρίως μέχρι τις 18 Αυγούστου, ενώ το ποσοστό των καταγεγραμμένων κρουσμάτων σε ενοίκους και εργαζομένους δεν ήταν ανησυχητικό. Κανένα περιστατικό δε χρειάστηκε νοσηλεία, ενώ δεν παρατηρήθηκε μεγαλύτερος αριθμός κρουσμάτων σε κάποιο συγκεκριμένο group ή σε κάποιο συγκεκριμένο όροφο του ξενοδοχείου και μεταξύ των κρουσμάτων υπάρχουν άτομα πολλαπλών εθνικοτήτων. Τα αποτελέσματα εργαστηριακού ελέγχου σε κλινικά δείγματα αναμένονται τις επόμενες ημέρες.
Το ΚΕ.ΕΛ.Π.ΝΟ. αναφέρει ότι δεν έχει ενημερωθεί για παρόμοιο συμβάν σε άλλες ξενοδοχειακές μονάδες της Ρόδου αυτή την περίοδο, ενώ δεν παρατηρείται αύξηση των κρουσμάτων γαστρεντερίτιδας στην κοινότητα πέρα από τα αναμενόμενα για την εποχή επίπεδα σύμφωνα με τις τοπικές υπηρεσίες υγείας. Το ΚΕΕΛΠΝΟ έχει ήδη ενημερώσει τους αρμόδιους Ευρωπαϊκούς φορείς δημόσιας υγείας σχετικά με το θέμα και σε συνεργασία με τους τοπικούς φορείς δημόσιας υγείας θα συνεχίσει να παρακολουθεί το φαινόμενο.
Πηγή: ethnos.gr
Σχόλια αναγνωστών
Τα σχόλια δημοσιεύονται κατόπιν έγκρισης.